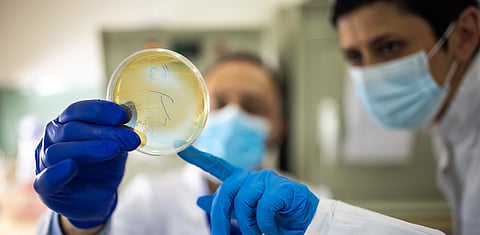
WAAW 2024: The world needs robust antimicrobial resistance surveillance systems

WAAW 2024: The world needs robust antimicrobial resistance surveillance systems
Antibiotics and vaccines stand among the most transformative medical innovations, revolutionising healthcare and saving millions of lives. However, antimicrobial resistance (AMR)—an unavoidable outcome of microbial evolution, with many resistance mechanisms still unknown—has already exacted a significant toll on human health, threatening the efficacy of essential therapies and medical procedures. In 2019, bacterial AMR alone directly caused 1.27 million deaths, with an additional 4.95 million deaths associated with drug-resistant infections, disproportionately impacting children under five. The economic toll of AMR could reach up to $1.2 trillion annually in a high-resistance scenario in the near future. Modelling studies often provide limited, one-time assessments, underscoring the need for robust surveillance systems to capture real-world data.
The World Health Organization’s 2015 Global Action Plan guides countries to enhance surveillance, infection prevention, antimicrobial stewardship, research, partnerships, and awareness to mitigate AMR. The WHO’s Global Antimicrobial Resistance and Use Surveillance System (GLASS) has led these efforts globally and highlights critical challenges like limited diagnostic capacity, workforce shortages, and inadequate information systems. Addressing these barriers is essential to achieving the 2024 Political Declaration’s target to reduce AMR-related deaths by 10 per cent by 2030. The availability of reliable AMR data is fundamental for formulating evidence-based policies to optimise antimicrobial stewardship.
Setting up a new AMR surveillance system—or strengthening an existing one—requires systematic, often concurrent and sequential processes. At the outset, a multidisciplinary team led by a microbiologist should be constituted, including data collectors, laboratory personnel, data managers, administrators, clinicians, and communication specialists. AMR surveillance can be conducted at an institutional level or as part of an external funding initiative, involving single or multiple centres across countries or regions. Surveillance may focus on analysing existing data or be designed as prospective studies to gather new information over time. Engagement with local health authorities and regular communication (through in-person or virtual meetings) is essential, especially in externally funded studies. A Data Sharing Agreement (DSA) should be signed by stakeholders to clarify responsibilities, data handling protocols, and security measures to prevent unauthorised access. In multicentric studies, the selection of participating laboratories should consider quality standards, project timelines, and funding availability.
AMR surveillance can range from focusing solely on laboratory data to incorporating patient demographics and clinical information, depending on the study’s scope. Local data collectors should ideally have experience in healthcare settings and receive comprehensive training on data entry procedures and troubleshooting. Once data is collected, it undergoes rigorous review for standardisation, and any ambiguities are clarified promptly. Data from positive cultures with antimicrobial susceptibility test (AST) results are analysed to estimate AMR rates, calculated as the proportion of non-susceptible isolates to a specific antimicrobial class over a defined period. Confidence intervals at the 95 per cent level are calculated to quantify uncertainties in resistance estimates. In addition to estimating AMR rates, supplementary analyses can help identify drivers of resistance when relevant data is available.
Results should be presented in a clear, accessible format, incorporating graphs, charts, and infographics to communicate findings effectively to diverse audiences. Disseminating results ensures they reach key stakeholders, inform policy, and support broader public health objectives. Findings can be shared through workshops, webinars, and conferences, providing opportunities for direct engagement with stakeholders to contextualise results and encourage collaboration. Publishing results in peer-reviewed journals adds credibility and contributes to the global body of AMR knowledge. At the same time, dissemination through digital platforms—such as social media, institutional websites, and AMR databases—can expand visibility and reach.
Conducting AMR surveillance involves several limitations, including challenges in data retrieval, variability in laboratory practices, limited data representation, and insufficient clinical data, all of which can impede the analysis of resistance drivers. Establishing feedback mechanisms is vital to assess the impact of disseminated results (e.g., how findings influence antimicrobial stewardship practices, treatment protocols, or funding decisions) and to refine communication strategies for future initiatives. Finally, documenting all dissemination activities is essential for future reference, helping to improve the design of dissemination strategies.
Geetanjali Kapoor is Acting Head and Researcher, One Health Trust (previously Center for Disease Dynamics, Economics & Policy [CDDEP])
Views expressed are the author’s own and don’t necessarily reflect those of Down To Earth